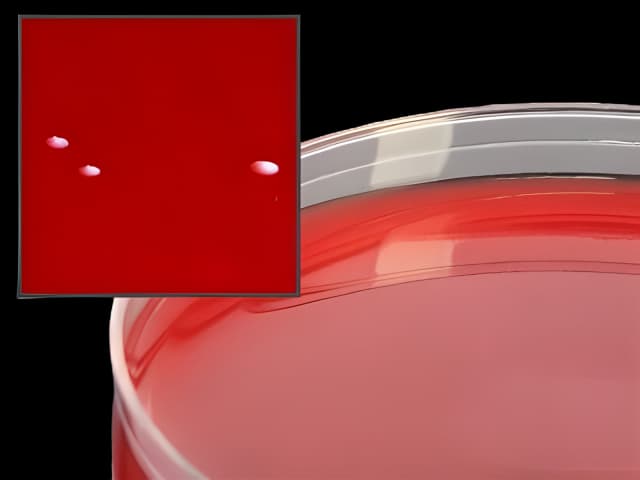
Prepared Media Anaerobic Phenylethyl Alcohol Agar (CDC formula) Mono-Plate Format

Prepared Media Anaerobic Phenylethyl Alcohol Agar (CDC formula) Mono-Plate Format
USAMP#34361315SKU: A90

Product Spotlight
- Anaerobic PEA (CDC formula), reducible, for anaerobes, 15 x 100 mm plate
- CDC formula with phenylethanol, 5% sheep blood, hemin, and vitamin K